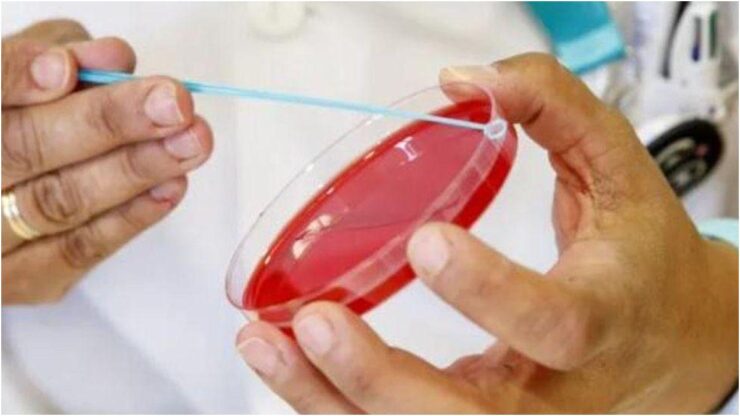

Le Isole Canarie chiuderanno il 2025 senza attivare lo screening del cancro della cervice su base popolazionale. La misura, annunciata per l’ultimo trimestre dell’anno, slitta al 2026 per esigenze tecniche legate al software e alla sua integrazione nella storia clinica. Nel frattempo, il programma di screening cervicale resta opportunistico. Contesto, protocolli e scadenze istituzionali definiscono il quadro fissato dal Ministero della Salute e dal Governo regionale.

Motivi del rinvio e integrazione software
La Consejería de Sanidad del Governo delle Canarie aveva previsto di avviare il progetto tra ottobre e dicembre, ma l’obiettivo è ora spostato al 2026, in linea con il termine ministeriale. Fonti sanitarie sottolineano la necessità di completare l’integrazione dell’applicativo nella cartella clinica elettronica, elemento chiave per un percorso organizzato di inviti, esami e referti.
“Il software è importante perché consente di gestire, pianificare e valutare sia gli appuntamenti sia i risultati. Deve essere integrato nella cartella clinica, quindi questo strumento è imprescindibile per avviare un programma di screening di popolazione”.
Inoltre, pur avendo concluso nel novembre 2024 lo sviluppo e l’integrazione nel sistema informatico Drago AP (Assistenza Primaria), rimaneva da completare l’aggancio all’Assistenza Specializzata. Di conseguenza, la complessità del processo impedisce di fissare già una data precisa per l’attivazione nel 2026. Ad oggi, nelle isole il controllo del cancro del collo dell’utero continua a essere effettuato in modo non organizzato.
Come funzionerà il protocollo
Il protocollo del screening cervicale prevede il prelievo dei campioni nei centri di salute. Successivamente, i materiali saranno inviati agli ospedali di riferimento per l’analisi. Tutti i laboratori ospedalieri del Servizio Canario di Salute (SCS) dispongono, dal 2024, di tecnologia e materiali idonei per questi studi. D’altro canto, tale dotazione già si utilizza nelle citologie con anomalie e nei casi collegati al virus del papilloma umano (HPV), infezione strettamente associata allo sviluppo della neoplasia cervicale.
Scadenze e calendario istituzionale
Nel 2019 il Ministero della Salute ha stabilito il cambio del sistema di rilevazione del cancro della cervice, concedendo alle comunità autonome cinque anni per avviare la trasformazione del programma e altri cinque per raggiungere una copertura prossima al 100% della popolazione bersaglio. In questo quadro, tra aprile 2021 e il 2025 la sanità canaria ha fissato più date di avvio, senza rispettarne alcuna.
Il primo calendario collocava l’inizio nel secondo semestre del 2021. Successivamente, il limite era il primo trimestre del 2022, poi giugno 2023 e fine 2024. A gennaio 2025, con il personale formato e i capitolati pubblicati per la citologia liquida —tecnica più avanzata rispetto alla tradizionale—, l’intenzione era di partire nell’ultimo trimestre di quest’anno. La nuova finestra operativa è il 2026.
Popolazione target e frequenza dei test
La popolazione d’interesse comprende le donne tra 25 e 65 anni. Tuttavia, il tipo di esame e la cadenza dipendono dall’età e dallo stato vaccinale contro l’HPV, secondo l’Ordine SND/454/2025 del 9 maggio.
Per le donne di 25-29 anni non vaccinate è prevista una citologia ogni tre anni. Per le vaccinate si applica un protocollo adattato in base al grado di implementazione del programma: può prevedere una citologia triennale oppure l’avvio dello screening a partire dai 30 anni.
Per le donne tra 30 e 65 anni, indipendentemente dallo stato vaccinale, è indicato il test HPV. Se il risultato è negativo, l’esame si ripete dopo cinque anni. Se è positivo, si effettua un triage mediante citologia; in assenza di segni di alto rischio, si ripete il test HPV a un anno per un follow-up più stretto.
Cos’è il cancro della cervice
Il cancro del collo dell’utero è un tumore a crescita lenta che origina dalla cervice uterina. Rappresenta la terza neoplasia ginecologica per frequenza. Oltre il 90% dei casi è associato all’HPV, infezione trasmessa soprattutto attraverso rapporti sessuali non protetti. In quest’ottica, uno screening del cancro della cervice strutturato e periodico è decisivo per individuare precocemente lesioni e ridurre l’incidenza di malattia invasiva.
Il rinvio del programma organizzato nelle Canarie fino al 2026, motivato dall’integrazione del software e dai passaggi tecnici ancora in corso, lascia per ora in atto solo verifiche opportunistiche. Le tappe fissate dal Ministero e il protocollo definito —con test HPV e citologia in base ad età e vaccino— restano la cornice operativa entro cui la sanità regionale punta a raggiungere la piena copertura della popolazione diana.